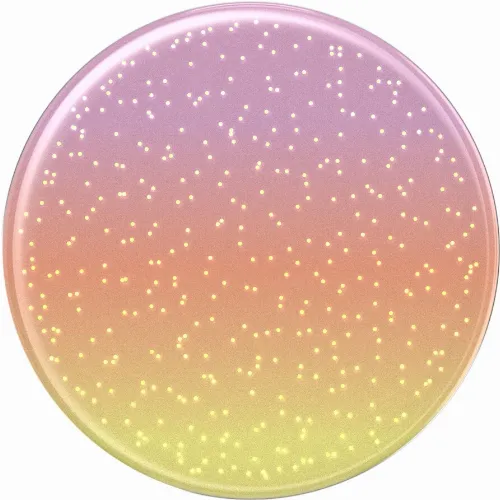

Product description
This is PopSockets
PopSockets creates fun, clever and expressive accessories that make using your phone easier and more personal. Their iconic PopGrip – a grip and stand in one – has sold over 230 million units worldwide. With a simple click, you get a better grip, hands-free viewing, and a way to show your style.
Today, PopSockets also offers phone cases, wallets and mounts – all designed with a focus on function, form and sustainability. Through initiatives like Poptivism and recycling programs with TerraCycle, they’re helping build a more sustainable future. With PopSockets, your phone becomes easier to handle – and more like you.
Specifications
| Product type | Phone grips |
Barcode(s)
| 840173746929 |